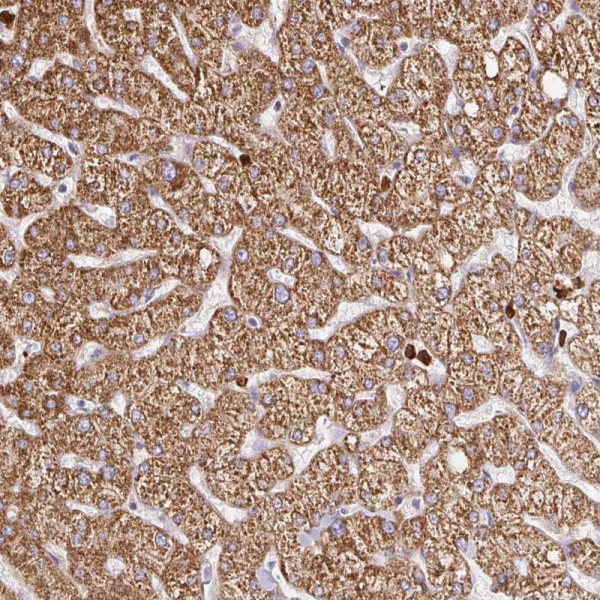
Anti-PDPK1

Cookie preferences
This website uses cookies, which are necessary for the technical operation of the website and are always set. Other cookies, which increase the comfort when using this website, are used for direct advertising or to facilitate interaction with other websites and social networks, are only set with your consent.
Configuration
Technically required
These cookies are necessary for the basic functions of the shop.
"Allow all cookies" cookie
"Decline all cookies" cookie
CSRF token
Cookie preferences
Currency change
Customer-specific caching
FACT-Finder tracking
Individual prices
Selected shop
Session
Comfort functions
These cookies are used to make the shopping experience even more appealing, for example for the recognition of the visitor.
Note
Show the facebook fanpage in the right blod sidebar
Statistics & Tracking
Affiliate program
Conversion and usertracking via Google Tag Manager
Track device being used
| Item number | Size | Datasheet | Manual | SDS | Delivery time | Quantity | Price |
|---|---|---|---|---|---|---|---|
| ATA-HPA035199.25 | 25 µl | - |
7 - 10 business days* |
330.00€
|
|||
| ATA-HPA035199.100 | 100 µl | - |
7 - 10 business days* |
463.00€
|
If you have any questions, please use our Contact Form.
You can also order by e-mail: info@biomol.com
Larger quantity required? Request bulk
You can also order by e-mail: info@biomol.com
Larger quantity required? Request bulk
Protein function: Serine/threonine kinase which acts as a master kinase, phosphorylating and... more
Product information "Anti-PDPK1"
Protein function: Serine/threonine kinase which acts as a master kinase, phosphorylating and activating a subgroup of the AGC family of protein kinases. Its targets include: protein kinase B (PKB/AKT1, PKB/AKT2, PKB/AKT3), p70 ribosomal protein S6 kinase (RPS6KB1), p90 ribosomal protein S6 kinase (RPS6KA1, RPS6KA2 and RPS6KA3), cyclic AMP-dependent protein kinase (PRKACA), protein kinase C (PRKCD and PRKCZ), serum and glucocorticoid-inducible kinase (SGK1, SGK2 and SGK3), p21-activated kinase-1 (PAK1), protein kinase PKN (PKN1 and PKN2). Plays a central role in the transduction of signals from insulin by providing the activating phosphorylation to PKB/AKT1, thus propagating the signal to downstream targets controlling cell proliferation and survival, as well as glucose and amino acid uptake and storage. Negatively regulates the TGF-beta-induced signaling by: modulating the association of SMAD3 and SMAD7 with TGF-beta receptor, phosphorylating SMAD2, SMAD3, SMAD4 and SMAD7, preventing the nuclear translocation of SMAD3 and SMAD4 and the translocation of SMAD7 from the nucleus to the cytoplasm in response to TGF-beta. Activates PPARG transcriptional activity and promotes adipocyte differentiation. Activates the NF-kappa-B pathway via phosphorylation of IKKB. The tyrosine phosphorylated form is crucial for the regulation of focal adhesions by angiotensin II. Controls proliferation, survival, and growth of developing pancreatic cells. Participates in the regulation of Ca(2+) entry and Ca(2+)-activated K(+) channels of mast cells. Essential for the motility of vascular endothelial cells (ECs) and is involved in the regulation of their chemotaxis. Plays a critical role in cardiac homeostasis by serving as a dual effector for cell survival and beta-adrenergic response. Plays an important role during thymocyte development by regulating the expression of key nutrient receptors on the surface of pre-T cells and mediating Notch-induced cell growth and proliferative responses. Provides negative feedback inhibition to toll-like receptor-mediated NF-kappa-B activation in macrophages. Isoform 3 is catalytically inactive. [The UniProt Consortium] Buffer: 40% glycerol and PBS (pH 7.2). 0.02% sodium azide is added as preservative. Highest antigen sequence identity to mouse: 93% and to rat: 95%
| Keywords: | Anti-PDK1, Anti-hPDK1, Anti-PDPK1, EC=2.7.11.1, Anti-3-phosphoinositide-dependent protein kinase 1 |
| Supplier: | Atlas Antibodies |
| Supplier-Nr: | HPA035199 |
Properties
| Application: | IHC |
| Antibody Type: | Polyclonal |
| Conjugate: | No |
| Host: | Rabbit |
| Species reactivity: | human |
| Immunogen: | Recombinant Protein Epitope Signature Tag (PrEST) antigen sequence: HSLSASDTGL PQRSGSNIEQ YIHDLDSNSF ELDLQFSEDE KRLLLEKQAG GNPWHQFVEN NLILKMGPVD KRKG (ATA-APrEST88296) |
Database Information
| KEGG ID : | K06276 | Matching products |
| UniProt ID : | O15530 | Matching products |
| Gene ID : | GeneID 5170 | Matching products |
| Protein Atlas Nr. : | ENSG00000140992 |
Handling & Safety
| Storage: | -20°C |
| Shipping: | +20°C (International: +20°C) |
Caution
Our products are for laboratory research use only: Not for administration to humans!
Our products are for laboratory research use only: Not for administration to humans!
Information about the product reference will follow.
more
You will get a certificate here
Viewed

